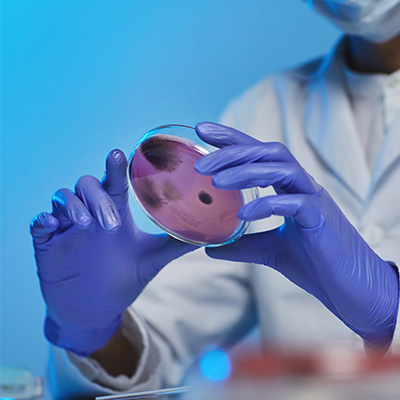
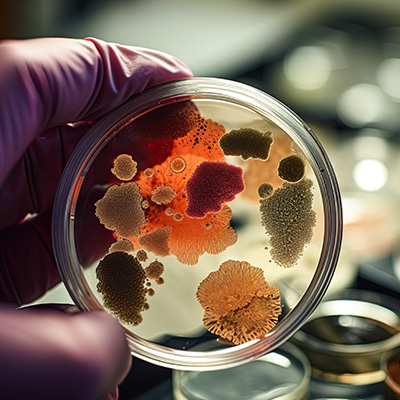

Enabling Technologies
Recent methodological advancements in ultra-sensitive analytics and single cell technologies are key for the acquisition of precise information about growth characteristics, physiological states and persistence phenotypes of bacteria in patients and in patient-like environments.
NCCR AntiResist uses advanced enabling technologies for the isolation and enrichment of specific pathogens and for the analysis of their specific physiology and genetic and proteome composition. This includes the development of enrichment techniques for specific pathogens and implementation of ultra-sensitive analysis tools such as proteomics, RNA-seq, metabolomics and flow cytometry.

In addition, we have established a toolbox of chemical and biological probes to visualise at single cell level the bacterial physiology during growth arrest and antibiotic-induced killing in vitro and under patient-like conditions.
Activities are closely aligned with existing Core Facilities like the Genomics, FACS, Imaging, Proteomics, sciCORE Center for Scientific Computing, Single-cell, and BSL3 Facilities.
Leadership of Enabling Technologies

Leader:
Marek Basler »

Co-leader:
Jan-Willem Veening »